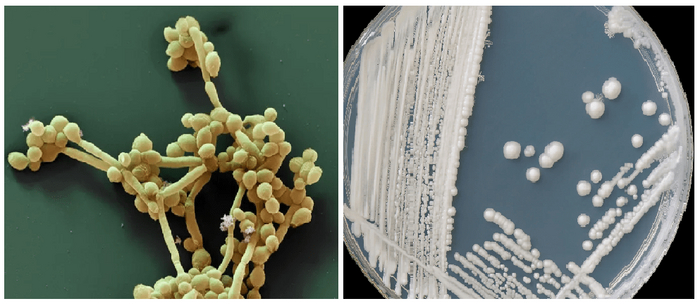

Постоянный голод и переедание. Как остановить жору и почему диеты не работают
Почему постоянный голод?
Те, кто хочет похудеть, знают, что больше всего мешает это сделать постоянное сильное чувство голода. Оно не даёт покоя и заставляет переедать. Именно оно является первопричиной лишнего веса, а не профицит калорий сам по себе. Бывает, что голод не проходит, даже когда мы плотно поели. Даже если у вас был полноценный обед, где вы съели суп, котлету и гарнир, но и после этого все еще такое ощущение, словно чего-то не хватает.
А бывает, что чувство голода просыпается неожиданно, и в голове словно крутится мысль: «Пойди, пойди, ну съешь что-нибудь. Там, в холодильнике, тебя ждёт что-то вкусненькое, бросай свои дела, иди перекуси!»
Знакомо ли вам такое ощущение? Я это называю неадекватным аппетитом.
Меня зовут Анна Савина, я диетолог, я помогла уже более 150.000 человек снизить вес. Я создатель авторской методики, стройное подсознание, благодаря которой вы можете снизить вес без спорта, без подсчёта калорий, просто правильно и сбалансировано, питаясь. Также, я автор марафона похудения “Ешь и стройней”, который вы можете пройти абсолютно бесплатно. В марафон включены 5 вводных вебинаров, которые рассказывают о методике и о том, как функционирует наш организм.
Как тело реагирует на пищу, которая поступает и почему большинство людей не могут похудеть. Вас также ждут вкусное меню на 7 дней из простых продуктов, которые есть у каждого под рукой.
Какой бывает голод: истинный, психологический, патологический
Итак, давайте поговорим о постоянном голоде. Откуда он берётся? В последнее время принято считать, что причины переедания и лишнего веса психологические. Это очень модное поверье, однако, я бы сказала, что причины в психологии кроются лишь отчасти. Правильнее будет сказать, что существуют 2 причины постоянного голода физиологическая и психологическая. И давайте вначале поговорим про физиологическую причину лишнего веса.
С этой точки зрения я разделила чувство голода на 2 разных типа.
Голод и аппетит в чем разница?
Первое из них неутолимый голод. Это когда вы едите и не можете наесться. Он возникает, как правило, после еды и чувство насыщения как будто не наступает. Кроме того, желание есть растёт во время еды, и иногда такое ощущение, что если бы вы не начинали есть, то вы бы спокойно обошлись без еды. А так как вы начали есть, то остановиться уже не можете. Именно поэтому многие на голодании легко сбрасывают вес, уезжают куда-нибудь в санаторий и худеют.
Но проблема в том, что мы не можем не есть совсем. И когда мы возвращаемся из санатория, то и вес возвращается обратно. Мы должны есть, чтобы жить. В этом вся загвоздка. И ниже я вам расскажу, как начать есть и суметь остановиться.
Второе чувство это неадекватный аппетит, который появляется не после еды, а ни с того ни с сего на ровном месте. Например, вы вечером уже поели часов в 7 или 8 и пошли смотреть телевизор. Вы уютненько устроились на диване, и вот, прошло уже час или полтора после еды, и тут появляется это чувство!!!
Вы вдруг вспоминаете, что в холодильнике есть еда, и эта мысль такая навязчивая, что вы никак не можете от неё избавиться. При этом желудок не чувствует голода как такового. Это ощущение именно в голове, что вы хотите и хотите снова что-то съесть?
Такие приступы неадекватного голода/аппетита могут возникнуть в любое время дня, не только вечером. И именно их принято считать психологическими причинами лишнего веса. Но на самом деле, причина этого состояния кроется не только в том, что вам скучно, одиноко или плохое настроение.
Неадекватный аппетит это проявление нарушенной работы мозга, по-другому это еще называется РПП. Но не пугайтесь, все исправимо и не так плохо.
Причины повышенного чувства голода
Итак, давайте рассмотрим, откуда берётся первое чувство голода — неутолимый голод. Дело в том, что, после еды у нас выделяется гормон насыщения, он называется гормон лептин. Этот гормон выделяется жировой тканью. Он поступает в гипоталамус и посылает в мозг два сигнала.
Сигнал номер один: хватит, есть, я не голоден. Сигнал номер 2: я хочу двигаться! Именно так происходит у здорового человека. После еды он чувствует прилив энергии и хочет поскорее выйти из-за стола и начать чем-нибудь заниматься. Может быть, прогуляться по улице, помыть посуду, вскопать грядки. То есть хочется что-то делать и это абсолютно нормально.
У человека, у которого работа лептина нарушена, такого не происходит. Лептин у него тоже выделяется и даже больше, чем у здорового человека, потому что у него, как правило, больше жира, но мозг на него не реагирует.
В чем причина?
А причина в другом гормоне, который называется инсулин. Именно избыточное количество инсулина блокирует гормон лептин.
Мозг просто не видит этот гормон. Такое состояние называется лептинорезистентность. Попробуйте сдать анализ на лептин. Если у вас количество лептина в крови повышено, значит, у вас лептинорезистентность, либо её зачатки. На самом деле, если у вас есть хотя бы 5 лишних килограммов, значит и без анализов понятно, что нарушение есть.
Хорошая новость заключается в том, что избавиться от лептинорезистентности можно довольно быстро. Для этого нужно привести гормон инсулин в порядок.
Постоянный голод что делать?
Гормон инсулин вырабатывается каждый раз при приёме пищи. Для того чтобы гормона инсулина в крови стало меньше, нужно создать инсулиновые окна — перерыв в приемах пищи, благодаря которым секреция инсулина приостановится.
Для этого нужно перестать питаться дробно и делать перекусы.
Нужно есть ровно три раза в день — завтрак, обед и ужин. Между приемами пищи ничего в ваш рот попадать не должно кроме воды, чая или кофе без сахара и молока. Ни морковка, ни фрукт, ни йогурт — ничего.
Таким образом, между приёмами пищи у вас должен быть 5-6 часовой перерыв, а между вечерним и утренним приемом пищи должно быть 10-12 часов.
Есть и еще одно условие, чтобы снизить гормон инсулин. О нем я расскажу чуть ниже.
Но прежде поговорим о неадекватном аппетите, давайте выясним как это работает?
Повышенный аппетит: диагностика
Дело в том, что каждый раз, когда мы употребляем еду, мы получаем наслаждение! И действительно, принятие пищи одно из высших земных наслаждений. Человеку стало мало простой еды и вместо того, чтобы есть то, что дает природа: фрукты, орехи, злаки, тушеные и сырые овощи, мясо, рыбу и т.д., мы стали искать и создавать невероятные вкусы.
Так появилась кулинария. Мука, сахар, усилители вкуса и другие вещества (я специально не называю их продуктами), которые делают вкусную пищу неадекватно вкусной.
Как побороть постоянный голод
Неадекватно вкусная пища дает нам неадекватное наслаждение. И как вы поняли, благодаря ей мы имеем неадекватный аппетит.
Посмотрите на рисунок, если вы съедите тарелку гречки, 2 яйца и огурец у вас выделится некоторое количество дофамина, вы тоже получите удовольствие, так заложено природой, что мы любим поесть.
Но если вы съедите пирожное или шоколад, или хлеб с маслом и с икрой, то удовольствие вы получите гораздо больше, и дофамина вы получите гораздо больше.
Дофамин это нейромедиатор, который лежит в основе всех зависимостей. Если мы посмотрим на сигареты, алкоголь, наркотики, кофе и любые другие виды зависимостей, они все действуют одинаково на наш мозг. Они воздействуют на дофаминовые рецепторы мозга. Тоже самое с нашим мозгом делает мука и сахар.
С чем связан постоянный голод
Посмотрите на картинке, как выглядит мука, сахар, кокаин и героин — вам не кажется, что здесь есть вполне конкретная взаимосвязь?
Это вещества, которые созданы для стимуляции мозга. Если вы употребляете героин, вы колете его в вену, пристрастились к алкоголю — употребляете его через рот, если это марихуана, то вы её курите и вдыхаете наркотик через легкие.
Ну а пищу нужно жевать. Все наркотики поступают по-разному в организм, но эффект от них получается одинаковый — кратковременное удовольствие, а потом мучительное ожидание повторения действия.
Если вы хотите снизить чувство постоянного голода, вам нужно просто заменить муку и сахар в рационе на фрукты, и неадекватная пищевая тяга вас покинет. Просто перестать есть стимуляторы это примерно как бросить курить. Немножко некомфортно, но терпимо.
Посмотрите на результаты моих учеников. Им удалось избавиться от огромного количества жира 30, 40, 50, 60 и более килограммов. Это невозможно сделать, если вы не избавитесь от зависимости. Невозможно избавиться от 50 килограммов, только занимаясь спортом или считая калории.
Нужно стать абсолютно чистым и трезвым. Кстати, воздержание от муки и сахара, также, как и воздержание от алкоголя, называется трезвость. А чрезмерное употребление еды по аналогии с употреблением алкоголя называется едоголизм.
Для того, чтобы вам было легко заменить сахар и муку на нормальную еду, ваш рацион должен быть полноценным, сбалансированным, разнообразным и красивым. Примерное меню я даю на моём бесплатном марафоне.
После того, как вы очистите свой рацион от этих токсичных продуктов, у вас снизится количество инсулина в крови, восстановятся дофаминовые рецепторы, и вы поймете, что вы едите не только потому, что у вас какие-то эмоциональные проблемы. Вы делаете это потому, что в теле возникает ненормальное, неадекватное желание, есть больше, чем обычно. И эта причина связана именно с тем, какой вид продуктов вы употребляете.
Если вы не знаете как составить меню и вписать полезные продукты в свой рацион, то приходите на мой бесплатный марафон. Вы увидите множество рецептов, которые я даю, и, благодаря которым, вы успешно похудеете. Вы узнаете, как вкусно, интересно, легко и комфортно можно худеть.
Записывайтесь и принимайте участие в Бесплатном марафоне похудения – быть следующим героем или героиней истории успеха вполне по вашим силам!
Инстаграм: Мой Инстаграм
Телеграм канал: Мой Телеграм-канал
Youtube: Мой Youtube-канал
С уважением, Анна Савина
Источник: https://annsavina.ruл